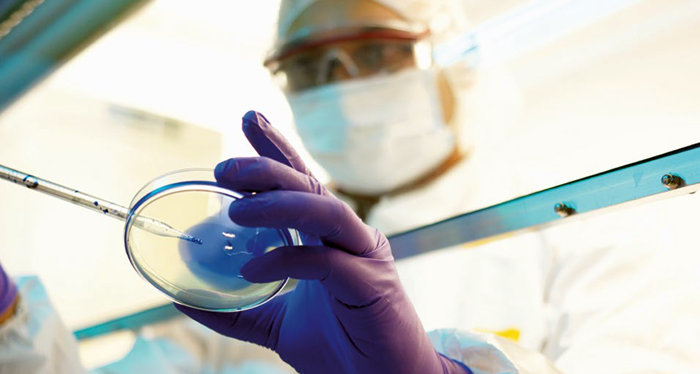

우리동네 맛집 소개 - 역삼역 가조쿠 식당
2024.12.26

일본 사장님께서 운영하시는 우리동네 맛집 - 가조쿠 식당입니다. 회사가 역삼역이라 매일 출근하니 뭐 우...
출처
https://blog.naver.com/sanbly1024/221129121559
이슈모어 핫이슈
관련 포스팅
Copyright blog.dowoo.me All right reserved.